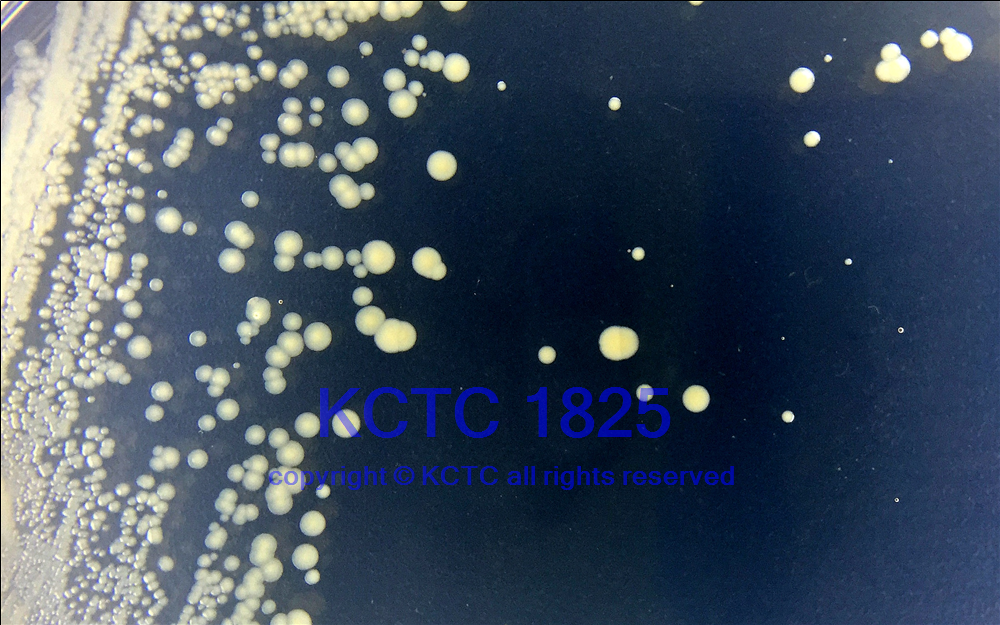

| 拉丁學(xué)名 | Alicyclobacillus acidocaldarius |
| 中文譯名 | 酸熱脂環(huán)酸芽孢桿菌 |
| 原始編號 | DSM 446 |
| 菌株來源 | ←DSMZ |
| 保藏人 | 周宇光 |
| 直接來源國家 | 德國 |
| 保藏時間 | 3/30/2015 |
| 其他保藏編號 | =ATCC 27009 =CIP 106131 =NBRC 15652 =JCM 5260 =NCIB 11725 KCTC 1825 |
| 生物危害 | 四類 |
| 模式菌株 | 模式菌株 |
| 培養(yǎng)溫度 | 60℃ |
| 培養(yǎng)基 | 1012 |
| 分離源 | 酸性熱泉 |
| 采集國家 | 美國 |
| Genbank(保藏人) | CP001727 |
| 價格 |